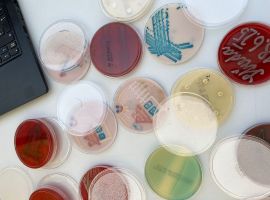
1000010419

Linkou metra C na zastávku Letňany nebo autobusovou dopravu na zastávku Výstaviště Letňany. Z konečné zastávky linky C – Letňany můžete do areálu PVA dojít pěšky nebo využít námi zajištěnou kyvadlovou autobusovou dopravu.
První spoj linky 872 odjíždí od stanice metra v 9:30. Naopak poslední spoj vyjíždí z areálu PVA v 18:00. Také můžete ze zastávky metra jet autobusem městské hromadné dopravy na zastávku Výstaviště Letňany. Na této zastávce zastavují linky 110, 140, 158, 195, 201 a 269.
Pokud se chystáte přijet soukromým autobusem, je možné krátce zastavit před výstavištěm, vystoupit a jet zaparkovat poblíž zastávky metra C Letňany na parkovišti P+R, které je vzdálené jen asi 5 minut chůze od výstaviště. Za celodenní parkovné zde zaplatíte 50 Kč. Méně doporučovanou možností je využít parkoviště přímo před výstavištěm. Zde stojí celodenní parkovné 150 Kč pro osobní automobily a 450 Kč pro autobusy. Kapacita tohoto parkoviště je omezená.